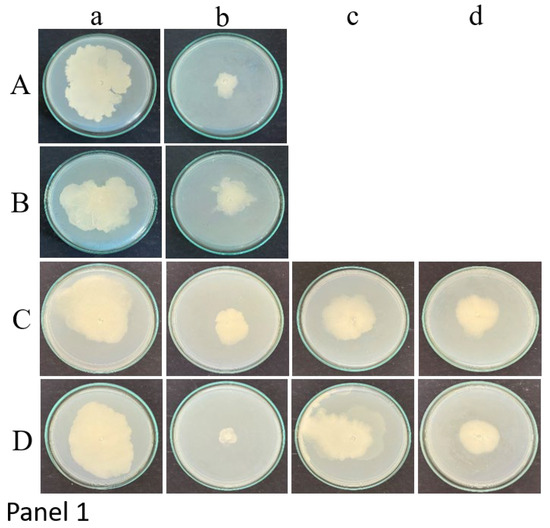

Abstract
Candida forms a gel-like biofilm in the Foley’s catheter (FC) causing tenacious biofouling and severe urinary tract infections (UTIs). For the first time, a spice extract-based antifungal lock therapy (ALT) has been developed to inhibit the Candida albicans gel matrix in FC. Aqueous extracts of garlic, clove, and Indian gooseberry were used as ALT lock solutions and tested against biofilm-forming multidrug-resistant clinical isolates of C. albicans. Reduction in the gel matrices formation in the catheter was confirmed by Point inoculation, MTT assay, CFU, and SEM analysis at 12 and 24 h of incubation. Garlic was effective in controlling both C. albicans M207 and C. albicans S470; however, clove and gooseberry effectively controlled the latter. As evidenced by CFU assay, there were 82.85% and 99.68% reductions in the growth of C. albicans M207 and S470, respectively, at 24 h of incubation. SEM revealed a switch from the biofilm to the yeast mode and a drastic reduction in cell numbers, with mostly clumped or lysed cells. The study will provide an impetus to the development of novel spice extract-based ALT, reducing the selection pressure on the pathogen and lowering antimicrobial resistance. Further research in this area has the potential to leverage clinical applications.
Keywords:
antifungal lock therapy; in situ; Foley’s catheter; gel; biofilm; spice extract; Candida albicans 1. Introduction
The Center for Disease Control and Prevention categorizes major Hospital Acquired Infections (HAIs) as Central Line-Associated Bloodstream Infections (CLABSIs), Catheter-Associated Urinary Tract Infections (CAUTIs), Ventilator Associated Pneumonia (VAP), and Surgical Site Infections (SSIs) [1]. About 3.2 million people are affected by HAIs in a year, implying that 1 in 31 hospital patients have one of the above-mentioned HAIs. The percentages of hospitalized patients affected by HAIs are 4% in Europe, 2.5–14.8% in Africa, and 10–30% in India. However, the incidence rate for HAIs in India ranges from 11–83%. CAUTIs occur in individuals whose urinary bladder is catheterized or will be catheterized within 48 h and can cause secondary bloodstream infections. They represent about 12–50% of overall hospitalized infections [2]. CAUTIs contribute to almost 80% of nosocomial Urinary Tract Infections (UTIs) [3]. This may be due to the fact that the catheterized patient’s urinary bladder is not emptied, which serves as a nidus for infection. CAUTIs can be caused by bacteria, such as Escherichia coli, Klebsiella, Enterococcus, Pseudomonas aeruginosa, Enterobacter spp., Staphylococcus spp., Proteus mirabilis, or fungi—mostly Candida albicans, Candida glabrata, Candida tropicalis, and rarely, Cryptococcus neoformans [4], which either enter through the bloodstream or retrograde via the urethra or bladder. Though the major causative agent of CAUTIs is a bacterial infection, fungi also contribute significantly, especially in hospital settings where there are patients already suffering Candidemia or who are immunocompromised. Amongst fungi, Candida (23%) species are the most common pathogen, with such infection being attributed to almost one quarter of disease cases [5,6]. These organisms form a self-produced gel matrix composed of polysaccharides, proteins, and DNA, called biofilms. They are the fourth leading hospital-associated infection. The highest rate of morbidity and mortality in CAUTIs is associated with Candida species [7,8], with more in the ICU setting [9,10].
Candida species in UTIs have an overall prevalence rate of 11.2%, with a high incidence rate of 59.7% in the age group between 21 and 30 years [11]. Pregnant women have a higher rate of UTIs (33%) than married women (27%) or single women (15%). Married males exhibited a higher (18%) prevalence of UTIs compared to single men (7%) [12]. Candida-associated CAUTIs become more serious in patients when they are drug-resistant. Multi-drug Candida species are more prevalent in hospital infections. People with UTIs caused by multidrug-resistant Candida species will have to try multiple drugs, which can lead to tissue and systemic toxicity, ultimately resulting in complicated side-effects.
Candida biofilm is a gel-like extracellular polysaccharide (EPS) matrix that anchors to the surface of medical devices. It can facilitate adhesion to medical devices causing their fouling and rendering them unfit for use. EPS acts as a natural gel that binds the microbial cells together to form cell aggregates or biofilm to protect the microorganism against abiotic and biotic stress. The formation of biofilm is most common in urinary catheters, especially FC [13], which may lead to severe cervical canal infections [14], urinary tract infections [15], and act as a cause for high-risk nosocomial candiduria [16]. These biofilms are made up of microbial cells along with gel-like EPS, which can vary in thickness and percentage composition. Infections caused by Candida species in the catheter lead to the removal of the infected catheter followed by antifungal therapy and then replacement with a new one [17]; however in some patients, it is not advisable for the catheter to be removed.
The lab on-a-chip technique has been used in recent times to study different aspects of Candida biofilms. Couttenier et al. studied the bending stiffness of C. albicans hyphae. They developed a microfluidic device to facilitate this. The cell morphology of C. albicans is defined by its mechanical properties and the bending stiffness varies depending on the environmental stress or genetic modifications. Their results proved that the cell wall of C. albicans is highly elastic and the organism has the ability to remodel entire hyphae in a matter of minutes [18]. In another study, a high-throughput microfluidic chip was used to screen 50,520 small molecules in combination with amphotericin B. Of the compounds screened, 10 showed a 30% improvement in the antifungal effect [19]. An in vitro microphysiological intestine-on-a-chip model was developed to study the microbial interaction of Lactobacillus rhamnosus and C. albicans. The colonization of L. rhamnosus on the chip reduced C. albicans-induced tissue damage and lowered the fungal load. This model facilitated the immune characterization and study of Candida pathogenesis [20]. Claudel et al. developed a lab-on-a-chip bio-impedance cytometry model to detect the electrical signature of a single yeast cell (Saccharomyces cerevisiae). This method was able to detect single cells and measure their size as well as their electrical properties [21].
ALT is used to clear the catheters of biofilms by applying a continuous infusion of antimicrobials, called ALT lock solutions, at high concentrations into the catheter lumen for extended periods [22]. To salvage the catheters, ALT can be applied either ex situ/ex vivo or in situ/in vivo. Some of the conventional ALT lock solutions for fungal biofouling are fluconazole [23], caspofungin [24,25], micafungin [24,26], amphotericin B [25], ethanol [27], and silver nanoparticles [28]. The concentration of conventional lock solutions is 10x times more than that of the therapeutic range. The use of high doses of conventional antimicrobials in the in vivo ALT has severe side-effects on the patient. It is also not very effective against multidrug-resistant organisms like C. albicans. This calls for an alternative ALT lock solution that can prevent toxic side-effects.
Spice, condiment, and herb extracts of garlic [29,30,31], cinnamon, clove, jasmine, rosemary [32], and Indian gooseberry (amla) extracts have potential antifungal effects with no known toxicity [33]. Therefore, antifungal spice extracts have prospects as natural and ALT lock solutions in preventing biofouling of catheters and thereby mitigating fungemia and septicaemia in affected patients. However, the effectiveness of ALT would depend on the choice, concentration, and time of incubation of the antifungal agents.
High-biofilm-forming drug-resistant clinical isolates of C. albicans cause extensive biofouling of medical devices and are a challenge to control using conventional antimycotic agents. The objective of this study was to address this issue by using three spice extracts—garlic (Allium sativum), clove (Syzygium aromaticum), and Indian gooseberry (Phyllanthus emblica)—as ALT lock solutions in the development of an in situ ALT to control the biofouling of FC by high-biofilm-forming multidrug-resistant clinical isolates C. albicans M207 and S470. Garlic, clove, and gooseberry have multiple antimicrobial properties. Garlic exhibits antifungal, antibacterial, anti-oxidant, anti-cancer, and anti-inflammatory properties [31,34]. Garlic has demonstrated antimicrobial activity against the ESKAPE group of bacterial pathogens [35,36]. Garlic also exhibits antifungal activity against C. albicans, Cryptococcus neoformans, Ascosphaera apis, Aspergillus niger, Fusarium oxysporum, Torulopsis, Trichosporon, and Rhodotorula spp. [37,38]. Allicin is the main component in garlic, constituting 70–80% of sulfur compounds. It has antimicrobial potential against bacteria, fungi, viruses, and parasites. This is due to its reaction with the thiol group of enzymes which can affect essential metabolism. The disruption of garlic releases enzymes like alliinase that convert alliin into allicin. However, allicin is highly unstable and can decompose into other stable organosulphur compounds, including allyl sulfide, diallyl sulfide, triallyl sulfide, ajoenes, etc, which also have a similar effect to allicin [39]. Garlic also contains free amino acids (1.2%), fiber (1.5%), protein (2%), organosulphur compounds (2.3%), carbohydrates (28%), and water (65%) [40]. Clove is known for its antifungal, antibacterial, antioxidant, analgesic, anti-infective, and anti-inflammatory properties [41,42,43]. It is effective against food-borne pathogens, such as Staphylococcus, Escherichia, Listeria, and Salmonella. It is also effective against Pseudomonas, Candida, and Klebsiella species. Clove has bioactive components, such as eugenol acetate, eugenol, caryophyllene, gallic acid, ellagic acid, biflorin, kaempferol, and quercetin. Gooseberry shows antioxidant, anti-cancer, chemoprotective, anti-viral, immunomodulatory, anti-aging, and anti-inflammatory properties. It is effective against Staphylococcus, and other multidrug-resistant cultures, due to the high level of phenolics. The phytochemicals present in gooseberry are gallic acid, ellagic acid, emblicanine A, emblicanine B, phyllantine, phyllatidine, quercetin, etc. [44]. The antimycotic activity of these extracts on C. albicans M207 and S470 was studied by point inoculation, MTT assay, colony forming unit assay, and SEM.
Previous studies with ALT have used conventional antimycotic agents. Studies with plant extracts have not been extended to ALT. This is the first study of its kind to investigate spice extract-based ALT developed to control the growth of biofilm-forming multidrug-resistant clinical isolates of C. albicans in Foley’s catheter. Further in situ studies on aqueous spice extract-based ALT would pave the way for its implementation in clinical practice.
2. Results and Discussion
2.1. Foley’s Catheter
Urinary catheters have been an important part of medical care since the invention of the FC. A typical FC has a capacity of 10 mL with a length of 400 mm. It has two channels, one called the drainage channel to discard the urine and a second inflation channel which helps to retain the catheter in the bladder [45]. The benefits of the FC also come with its innate risks. When used frequently and for prolonged periods, it can become a niche for various microorganisms, especially biofilm-formers that can become a lasting source of acute to severe Urinary Tract Infections (UTIs) and other life-threatening infections.
2.2. Point Inoculation
Large spreading biofilm phenotypes of C. albicans M207 and S470 cultures were grown in 12 and 24 h control plates with the catheter section and, as expected, more growth was observed at 24 h. Both the center and peripheral sections of the catheter when point-inoculated on TSA media exhibited a similar extent of growth, indicating uniform growth of the culture throughout the catheter.
Point inoculation of the garlic extract-treated section of the catheter with C. albicans M207 showed substantial inhibition in growth along with a drastic regression of the biofilm for both 12 and 24 h of incubation (Figure 1).
Figure 1.
Panel 1: Point inoculation of the catheter sections at 12 h of incubation for (a) control, (b) garlic, (c) clove, and (d) gooseberry extracts. (A) C. albicans M207 center, (B) C. albicans M207 periphery, (C) C. albicans S470 centre, (D) C. albicans S470 periphery. Panel 2: Point inoculation of the catheter sections at 24 h of incubation for (a) control, (b) garlic, (c) clove, and (d) gooseberry extracts. (A) C. albicans M207 center, (B) C. albicans M207 periphery, (C) C. albicans S470 centre, (D) C. albicans S470 periphery.
Catheters with C. albicans S470 were treated with extracts of garlic, clove, and gooseberry extracts. All three extracts were found to be effective in controlling the biofilm at 12 and 24 h of incubation (Figure 1). However, among them, garlic was the most effective, followed by clove and then gooseberry.
2.3. MTT Assay
MTT assay was also performed for the center and periphery sections of the catheters of the 12 (Figure 2, Panel 1) and 24 h grown cultures (Figure 2, Panel 2) for the reconfirmation of uniform growth in the catheter. This assay also helps to directly confirm the viability and indirectly the inhibition of C. albicans M207 against garlic extract and of C. albicans S470 against garlic, clove, and gooseberry extracts. Amongst these three extracts, for C. albicans, S470 the most effective was garlic, followed by clove and gooseberry.
Figure 2.
Panel 1: MTT assay of center and periphery regions of the catheter having C. albicans M207 and C. albicans S470 grown for 12 h and treated with garlic, gooseberry, and clove. * p ≤ 0.05, ** p ≤ 0.01. The asterisk indicates a significant difference with respect to the control. Panel 2: MTT assay of center and periphery regions of catheter having C. albicans M207 and C. albicans S470 grown for 24 h and treated with garlic, gooseberry, and clove. **** p ≤ 0.0001. The asterisk indicates a significant difference with respect to the control.
For 12 h of incubation, C. albicans M207 showed 86% viability at the center and 89% at the periphery region when treated with garlic. However, at 24 h of incubation, on treatment, the viability decreased to 71% at the center and 72% at the periphery regions. C. albicans S470 at 12 h of incubation with the extracts showed a percentage viability of 75% for garlic, 92% for clove, and 96% for gooseberry at the center, and a percentage viability of 76% for garlic, 86% for clove, and 94% for gooseberry at the periphery region. However, at 24 h of incubation, the percentage viability was only 45% for garlic, 69% for clove, and 62% for gooseberry at the center, and at the periphery, 48% for garlic, 57% for clove, and 62% for gooseberry. The targeted extracts were found to be efficacious in inhibiting the biofilm of both the cultures in the center as well as the peripheral regions of the catheter with 24 h application being more effective than 12 h.
The MTT assay confirmed the antimicrobial activity of the spice extracts against the tested multidrug-resistant clinical isolates of C. albicans.
2.4. Colony-Forming Units (CFUs)
The quantity of CFUs was determined for C. albicans M207 with garlic extract (Figure 3: Panel 1, Table 1) and for C. albicans S470 (Figure 3: Panel 2, Table 2) with garlic, clove, and gooseberry at 12 and 24 h of incubation.
Figure 3.
Panel 1: CFUs of (A) C. albicans M207 control treated with (B) garlic extract at 12 and 24 h of incubation. (a) 12 h neat, (b) 12 h 10−1 dilution, (c) 24 h neat, (d) 24 h 10−1 dilution. Panel 2: CFUs of (A) C. albicans S470 control treated with (B) garlic, (C) gooseberry, and (D) clove extracts at 12 and 24 h of incubation. (a) 12 h neat, (b) 12 h 10−1 dilution, (c) 24 h neat, (d) 24 h 10−1 dilution.
Table 1.
CFU results of C. albicans M207 treated with garlic extract at 12 and 24 h of incubation.
Table 2.
CFU results of C. albicans S470 treated with garlic, clove, and gooseberry extracts at 12 and 24 h of incubation.
Garlic was very effective in inhibiting C. albicans M207 and S470, followed by clove and gooseberry for the latter.
It can be observed that 12 and 24 h of incubation for C. albicans M207 with garlic extract had the same % kill of 82.35% at 10−1 dilution. At the same dilution, for C. albicans S470, inhibition with garlic was 98.42% and 99.68% for 12 and 24 h, respectively. The percentage kill for clove was 97.6% and 95.54% for 12 and 24 h, respectively, and the percentage kill for gooseberry was 97.6% and 95.6% for 12 and 24 h, respectively.
The colonies appeared to be smaller and more in number at 12 h of incubation; however, at 24 h the colonies appeared to be bigger, and less in number. The higher dilutions of the CFU (10−2, 10−3, 10−4) are shown in Figures S1–S4.
2.5. Scanning Electron Microscopy
Since the surface area exposed is less in the cross-section (Figures S5 and S6) of the catheter as opposed to the longitudinal section, the details revealed in the SEM images of the latter were far superior to the former, especially with respect to the morphology of the cells and the EPS gel. Abundant cells embedded in the thick EPS gel matrix can be observed in the control images of C. albicans M207 and S470 at 12 and 24 h (Figure 4) of incubation. In the images of C. albicans M207 treated with garlic extract for 12 h, we can observe clumped and dead cells enmeshed in the almost negligible gel matrix; however, at 24 h of incubation, the patches of clumped cells have mostly reduced, revealing the distorted EPS gel in the background. Likewise, the micrographs of the garlic, clove, and gooseberry-treated C. albicans S470 for both time durations also revealed clumped and dead cells in the diminished EPS gel. Here too, garlic was the most effective in inhibiting the pathogenic yeast. In the images of the clove- and gooseberry-treated catheter sections, a few cells embedded in the EPS gel are still seen.
Figure 4.
SEM analysis of the longitudinal section of the catheter. Panel 1: Blank catheter. Panel 2: (A) C. albicans M207 at 12 h, (B) C. albicans S470 at 12 h, (C) C. albicans M207 at 24 h and (D) C. albicans S470 at 24 h. (a) Control, (b) garlic-treated, (c) gooseberry-treated, (d) clove-treated.
The SEM analysis confirms the effectiveness of the spice extracts against C. albicans M207 and S470, which was previously observed through the Point inoculation, CFU, and MTT assays.
2.6. Discussion
Biofilm and the associated pathogen infections are a major problem in implants, especially in catheters, and are recalcitrant to conventional antimicrobials [46]. The major classes of conventional antifungals are azole (fluconazole, voriconazole, itraconazole, etc.), echinocandin (caspofungin, micafungin, anidulafungin, etc.), polyene (amphoterecin B, nystatin, natamycin, etc.), allylamine (terbinafine, naftifine, tonaftate, etc.), and miscellaneous (griseofulvin, flucytosine, etc.). Conventionally, to salvage the catheter in patients, antimycotics such as caspofungin and amphotericin B have been used in antimicrobial lock therapy [47]. For lock therapy, a lock solution should have the following characteristics: high stability, low potential to resistance, cost-effective, non-toxic, ability to penetrate the EPS gel, target specificity [27]. Conventional antimicrobials such as Caspofungin and Amphotericin B have been used previously as lock solutions in inhibiting Candida organisms [48]. Azoles such as fluconazole and voriconazole are effective in removing Candida biofilms [48]. Nikkomycin Z in combination with echinocandins is reported as a good possible adjuvant in lock therapy [49]. However, in another study with the same agents, the results were found to be negative [50]. Some of the classes of antifungal agents and their effects on Candida are as follows: Azoles can inhibit ergosterol synthesis by blocking lanosterol 14α demethylase; echinocandins affect the cell wall by blocking β-glucan synthesis; polyenes attack the plasma membrane binding to ergosterol; allylamine inhibits squalene epoxidase, which is an essential enzyme in the ergosterol pathway. Griseofulvin, a polyketide miscellaneous class of antifungal agents, blocks mitosis by preventing the synthesis of microtubules and microfilaments. Flucytosine, a nucleotide analogue also classified under miscellaneous antifungals, inhibits the synthesis of nucleic acids (Figure 5).
Figure 5.
The proposed mechanism of action of allicin, eugenol/ellagic acid, and gallic acid of garlic (pink arrow), clove (black arrow), and gooseberry (green arrow), respectively, on Candida sp. Allicin causes cellular damage, affects the sodium–potassium pump, affects lipid synthesis, causes lipid peroxidation, inactivates thiol peptide (glutathione) and proteins (glutathione peroxidase, glutathione reductase, coenzyme A) that act as innate antioxidants, leading to oxidative stress, thereby also triggering ROS generation, damages mitochondria, reduces succinate dehydrogenase, produces ROS, which, in turn, cause cytochrome C release, caspase activation and apoptosis, inhibits ECE1 virulence factor/candidalysin, and inactivates quorum-sensing genes. Eugenol/ellagic acid causes cellular damage, releases cytochrome C, leading to caspase activation and apoptosis, produces ROS, releases nucleic acid and proteins, inhibits ECE1 virulence factor/candidalysin, and forms DNA adducts. Gallic acid causes cellular damage, leading to cytoplasmic leakage, damage to nucleic acid and proteins, and inhibits RNA synthesis. Classes of conventional antimycotics (azole, allylamine, echinocandins, polyenes, the miscellaneous class—griseofulvin, and nucleotide analogues) and their binding sites are also depicted in the figure.
Repeated use of conventional ALT can be harmful to the body due to the high concentrations of the ALT drugs and their side-effects. Previous publications have shown the effective inhibition of Candida species with garlic [51], clove [32], and gooseberry extracts [52] as alternative therapies. The major component in garlic extract is allicin, in gooseberry is gallic acid, and in clove is eugenol or ellagic acid [53]. We have also obtained similar results through LCMS in our previous study. In clove, however, the major compound detected was ellagic acid [51]. The active principles of garlic (allicin), clove (eugenol and ellagic acid), and gooseberry (gallic acid) enter the cells by simple diffusion. Garlic extract damages the cell wall and causes cell collapse. In its multi-mode action, it affects lipid synthesis, reduces oxygen consumption, inhibits succinate dehydrogenase in the Krebs cycle, and inactivates thiol peptide (glutathione) and proteins (glutathione peroxidase, glutathione reductase, coenzyme A) that act as innate antioxidants, leading to oxidative stress, thereby also triggering ROS generation. It can also alter gene expression involved in oxidative reduction processes, damage mitochondria, and downregulate the ECE1 virulence factor that encodes candidalysin [54]. The extract can also affect the sodium-potassium pump and inactivate quorum-sensing genes. The clove extract binds to ergosterol on the cells and disrupts the cell membrane. It enters the cell and inhibits toxin production, releases intracellular components like radicals, cytochrome C, ions, protein, nucleic acid, etc., and affects the transport of ions and ATP, leading to cell death. It is also known to inhibit adhesion and biofilm formation along with inhibiting toxin production [55,56]. The components in gooseberry extract destroy the cell wall, leading to cytoplasm leakage, damaging protein, DNA, and RNA, and disrupting enzymatic activity. Of the components, alkaloids alter the genetic material of microbes, phenols like ellagic acid and gallic acid control the protein and lipid ratio, flavonoids inhibit RNA synthesis, and tannins inhibit oxidative phosphorylation [57,58]. The antifungal activity of these active principles of garlic, gooseberry, and clove depends on the quantity of the major components present; however, it is difficult to identify the specific site of action as several interactive reactions occur simultaneously [55,59,60].
Hence, we used these aqueous extracts as ALT lock solutions in place of first-line antimycotics to inhibit biofilm buildup of multi-drug-resistant clinical isolates of C. albicans M207 and S470. CFU and MTT assay were used to monitor the cell viability and metabolic activity of the Candida cultures on treatment with the spice extracts [61,62]. In our earlier publication, we observed that C. albicans biofilm, when grown on a polystyrene surface, has an MIC 50 of 1 mg at 12 h of incubation for aqueous garlic extract and at 24 h, persister cells further enhanced the growth of C. albicans. In the coculture of C. albicans M207 and E. coli until 12 h, the biofilm was mostly contributed by the latter; however, at 24 h, the former overcame the inhibitory effect of the latter and the biofilm was mostly contributed by C. albicans M207 [30]. However, in the present study, when garlic-treated C. albicans M207 was grown in the FC, even up to 24 h, a significant reduction in the viability of cells was observed, mostly due to the difference in the gel matrix in the lumen of the silicone elastomer catheters, as opposed to growth on the surface of the silicone elastomer disks. In all probability, the EPS gel in the catheter is still in its exponential phase and has not developed into a fully mature one [63].
As in this study, Mukherjee et al., 2009 in SEM analysis, also observed debris and dead cells on treatment with conventional antimicrobials [64]. Ionesce et al., 2021 observed a uniform growth of biofilm in the intravesical and intraluminal FC; however, cluster formation was observed in the latter [13]. A comparison of our study with published work is presented in Table 3.
Table 3.
A comparative study of the current work with published literature.
The whole spice extracts used in the study showed very effective inhibition of C. albicans in the FC. These extracts have multiple active principles present in them which are responsible for their antimicrobial property. However, purified active compounds alone or in combination with first-line antimycotics may play a very important role as future therapeutics for the treatment of Candida-infected catheters in vivo.
3. Conclusions
The growth of C. albicans was induced on FC and effectively controlled using garlic, gooseberry, and clove in an ALT setup. Though ALT has its strengths, the limitations are that the success of the therapy depends on the species and the strain of pathogen involved. In our case, the C. albicans M207 strain can only be inhibited with aqueous garlic extract, whereas the C. albicans S470 strain can be inhibited with garlic, gooseberry, and clove. Multiple doses may assist in eliminating C. albicans species in the catheter. The dose depends on the eukaryotic nature and the ergosterol availability on the species’ cell wall. Since no organic solvents are used in the extract preparation, it is environmentally friendly and incorporates intrinsic safety into the therapeutic preparation. As in precision medicine, it is not just the pathogenic species that needs to be considered but also the strain. Hence, the future scope of the spice extract-based ALT would involve testing with other pathogenic species of yeasts and bacteria. In vivo studies in the future will also help in customizing solutions for the elimination of cells within EPS gels, thereby avoiding catheter-related infections. The ALT method developed is rapid, affordable, easily adaptable, and scalable worldwide across communities. The study offers a viable basis for developing and creating natural in situ ALT treatment options with aqueous garlic extract, either alone or as a robust combinatorial and synergistic design to treat drug-resistant indwelling catheter-associated Candida biofilm infections.
4. Materials and Methods
4.1. Yeast Cultures
Clinical isolates of C. albicans M207 and S470 were used in the study. C. albicans M207 was isolated from the umbilical vein catheter of a female baby, and C. albicans S470 was isolated from the sputum of a female patient. Both the patients were affected with invasive Candidiasis. The cultures were kindly provided by the Microbiology Laboratory, M S Ramaiah Medical College and Teaching Hospital, Bengaluru, Karnataka, India.
Ethical clearance was not required as no human subjects were involved in the study.
4.2. Growth Conditions
C. albicans M207 and S470 were sub-cultured on Trypticase Soy Agar (TSA) medium and incubated at 32 °C for 24 h. The clinical isolates were stored as glycerol stocks (15% v/v) at −20 °C for short-time experiments; however, the mother cultures were stored at −86 °C.
4.3. Catheter
A silicone-based FC (RUSCH) was used for the study. The cultures were grown in the lumen of the catheter for the induction of biofilm and to test the antifungal lock therapy.
4.4. Extract Preparation
The shelled garlic bulbs, fresh pitted Indian gooseberry fruit (amla), and whole clove buds were carefully chosen for the study as they are known to have antimicrobial properties. These three natural sources were chosen as our previous studies have demonstrated that aqueous garlic extract can effectively control biofilms of C. albicans M207 and C. albicans S470 and clove and Indian gooseberry can also control the latter [30,51]. Garlic, clove, and Indian gooseberry were locally sourced and authenticated by the Pharmacognosy Department, The Himalaya Drug Company, Makali, Bengaluru. Initially, the samples were washed in tap water followed by sterile water and air-dried before extraction. A weight of 10 g each of shelled garlic cloves and pitted gooseberry fruit was crushed in a pestle and mortar with 5 mL of sterile water, whereas a weight of 5 g of powdered clove was dissolved in 10 mL of sterile water. The extracts were centrifuged at 1000 rpm for 10 min at 4 °C. The supernatant was filtered through Whatman filter paper and was used for further studies [30]. The crude extracts have been characterized and the active principles have been detected via LCMS analysis in our previous study [51].
4.5. Pre-Inoculum
A loopful of C. albicans M207 and of S470 were inoculated separately in test tubes with 5 mL of TSB medium, sealed, and incubated overnight in a shaker incubator at 32 °C. The next day, the optical density was read, and the culture inoculum was adjusted to a cell count of 1 × 106 cells/mL for further experiments.
4.6. In Vitro Induction of Candida albicans Biofilm in Foley’s Catheter and Spice Extract-Based Antifungal Lock Therapy (ALT)
Pre-inoculated cultures were adjusted to a cell density of 1 × 106 cells/mL. The extracts of garlic (200 mg dry weight), clove (43 mg dry weight), and Indian gooseberry (86 mg dry weight), were prepared and kept ready. The in vitro ALT was applied by mixing the culture and the extract in a ratio of 1:1 along with a control plate in parallel. C. albicans M207 was treated with garlic extract and C. albicans S470 was treated with garlic, gooseberry, and clove extracts, respectively. FC tube was cut into 10 cm long pieces. One end of the catheter was sealed with parafilm, and the culture-spice extract mixture was added into the catheter from the other end and sealed with parafilm. The catheter was then incubated in an incubator at 32 °C for 24 h. The next day, the culture was removed from the catheter and washed with phosphate-buffered saline (PBS). Using a sterile blade, thin sections of the catheter were cut at the center and periphery regions and used for further experimentation.
4.7. Point Inoculation
Thin sections of the catheter cut from the center and periphery region of the catheter were placed at the center of TSA plates and incubated for 16 h at 32 °C. The growth of the culture biofilm was observed the following day.
4.8. MTT Assay
Thin sections of the center and periphery regions of the catheters with 12 and 24 h grown cultures were placed in a 96-well microtiter plate. MTT (5 mg/mL) solution was added to each of the wells and incubated for 3 h. After the incubation period, the MTT was discarded, and acidified isopropanol was added to each well and incubated for 20 min. The wells were vigorously mixed and thereafter 100 µL aliquot was transferred to a fresh well and the absorbance was read at 540 nm using a microplate reader (BioTek, Bengaluru, India).
4.9. Colony-Forming Units (CFUs)
C. albicans cultures were grown inside the Foley’s catheter as discussed in Section 4.6. The catheter cross-sections were added into Eppendorf tubes with 1 mL PBS each. With vigorous mixing, the cells from the catheter sections were detached into the PBS solution. A serial 10-fold dilution of the control and treated samples was performed. Each of the dilutions up to 10−4 was vortexed thoroughly and a volume of 100 µL of the serially diluted samples was evenly spread on TSA plates by the spread plate method and the plates were incubated at 32 °C for 24 h. After incubation, the number of colonies was counted by a conventional manual method, and the CFU concentration was calculated as per Equation (1). The images of the Petri plates were also captured and documented.
CFU/mL = No. of colonies × Dilution factor/Volume of culture plated
The percentage kill of the C. albicans cultures was calculated as mentioned below.
% Kill = (Control-Treated)/Control × 100
4.10. Scanning Electron Microscopy
After the incubation periods of 12 and 24 h, the lumen of the catheter was washed with PBS and the catheter was sliced vertically and horizontally to obtain a longitudinal section (LS) and cross-section (CS). The LS and CS were then dipped in a 4% glutaraldehyde fixative for 1 h followed by a PBS wash. The sections were further dehydrated in a series of ethanol washes and later air-dried and stored for further studies [51]. The sections were mounted on an SEM stub and sputtered with gold. The images were captured at 2500× magnification using a JSM-IT300 scanning electron microscope at AFMM, Indian Institute of Science, Bengaluru, India.
4.11. Statistical Analysis
Three independent trials were performed for all the experiments. Values of broth microdilution were expressed as mean ± standard deviation. The treated samples were compared with their respective controls. Statistical analysis was conducted by two-way ANOVA with a p-value of ≤0.05 as statistically significant.
Supplementary Materials
The following supporting information can be downloaded at: https://www.mdpi.com/article/10.3390/gels11010023/s1, Supplementary Materials S1: Figure S1: CFU of (A) C. albicans M207 control treated with (B) garlic extract at 12 h of incubation. (a) 10−2, (b) 10−3, (c) 10−4 dilutions. Figure S2: CFU of (A) C. albicans M207 control treated with (B) garlic extract at 24 h of incubation. (a) 10−2, (b) 10−3, (c) 10−4 dilutions. Figure S3: CFU of (A) C. albicans S470 control treated with (B) garlic, (C) gooseberry, and (D) clove extracts at 12 h of incubation. (a) 10−2, (b) 10−3, (c) 10−4 dilutions. Figure S4: CFU of (A) C. albicans S470 control treated with (B) garlic, (C) gooseberry, and (D) clove extracts at 24 h of incubation. (a) 10−2, (b) 10−3, (c) 10−4 dilutions. Figure S5: SEM analysis of the cross-section of a catheter for (A) C. albicans M207 and (B) C. albicans S470 at 12 h. (a) Control, (b) Garlic treated, (c) Gooseberry Treated, (d) Clove treated. Figure S6: SEM analysis of the cross-section of a catheter for (A) Blank, (B) C. albicans M207, and (C) C. albicans S470 at 24 h. (a) Control, (b) Garlic treated, (c) Gooseberry Treated, (d) Clove treated. Supplementary Material S2: Enlarged images of Figure 4, Figures S5 and S6.
Author Contributions
Conceptualization, B.S.; methodology, B.S.; validation, B.S.; formal analysis, B.S. and K.S.; investigation, B.S., V.V., A.R., H.S., M.G., N.K.K.N. and N.M.D.; resources, B.S.; data curation, B.S., V.V. and K.S.; writing—original draft preparation, V.V.; writing—review and editing, B.S., V.V. and K.S.; visualization, B.S.; supervision, B.S.; project administration, B.S.; funding acquisition, B.S. All authors have read and agreed to the published version of the manuscript.
Funding
This research was funded by THE KARNATAKA STATE COUNCIL FOR SCIENCE AND TECHNOLOGY (KSCST), grant number 7.1.01/SPP/10.
Institutional Review Board Statement
Not applicable.
Informed Consent Statement
Not applicable.
Data Availability Statement
The original contributions presented in this study are included in the article/Supplementary Materials. Further inquiries can be directed to the corresponding author.
Acknowledgments
The authors wish to thank Beena, Rameez Raja, and Indumathi from the Microbiology Lab at Ramaiah Teaching Hospital, Bengaluru for providing us with the C. albicans clinical isolates.
Conflicts of Interest
The authors declare no conflicts of interest. The funders had no role in the design of the study; in the collection, analyses, or interpretation of data; in the writing of the manuscript; or in the decision to publish the results.
Abbreviations
| FC | Foley’s Catheter |
| UTI | Urinary Tract Infections |
| ALT | Antifungal Lock Therapy |
| MTT | 3-(4,5-Dimethylthiazol-2-yl)-2,5-diphenyltetrazolium bromide |
| CFU | Colony-Forming Unit |
| SEM | Scanning Electron Microscopy |
| HAI | Hospital Acquired Infections |
| CLABSI | Central Line-Associated Bloodstream Infections |
| CAUTI | Catheter-Associated Urinary Tract Infections |
| VAP | Ventilator-Associated Pneumonia |
| SSI | Surgical Site Infections |
| DNA | Deoxyribonucleic Acid |
| ICU | Intensive Care Unit |
| EPS | Extracellular Polysaccharide |
| ESKAPE | Enterococcus faecium, Staphylococcus aureus, Klebsiella pneumoniae, Acinetobacter baumannii, Pseudomonas aeruginosa, Enterobacter spp. |
| LCMS | Liquid Chromatography Mass Spectrometry |
| ATP | Adenosine Triphosphate |
| RNA | Ribonucleic Acid |
| ROS | Reactive Oxygen Species |
| MIC | Minimum Inhibitory Concentration |
| TSA | Trypticase Soy Agar |
| PBS | Phosphate-Buffered Saline |
| LS | Longitudinal Section |
| CS | Cross-Section |
References
- Sikora, A.; Zahra, F. Nosocomial Infections. In StatPearls; StatPearls Publishing: Treasure Island, FL, USA, 2023. [Google Scholar]
- D’Incau, S.; Atkinson, A.; Leitner, L.; Kronenberg, A.; Kessler, T.M.; Marschall, J. Bacterial Species and Antimicrobial Resistance Differ between Catheter and Non-Catheter-Associated Urinary Tract Infections: Data from a National Surveillance Network. Antimicrob. Steward. Healthc. Epidemiol. 2023, 3, e55. [Google Scholar] [CrossRef] [PubMed]
- Venkataraman, R.; Yadav, U. Catheter-Associated Urinary Tract Infection: An Overview. J. Basic Clin. Physiol. Pharmacol. 2023, 34, 5–10. [Google Scholar] [CrossRef] [PubMed]
- Rubi, H.; Mudey, G.; Kunjalwar, R. Catheter-Associated Urinary Tract Infection (CAUTI). Cureus 2022, 14, e30385. [Google Scholar] [CrossRef] [PubMed]
- Majumder, M.M.I.; Ahmed, T.; Ahmed, S.; Khan, A.R.; Majumder, M.M.I.; Ahmed, T.; Ahmed, S.; Khan, A.R. Microbiology of Catheter Associated Urinary Tract Infection. In Microbiology of Urinary Tract Infections—Microbial Agents and Predisposing Factors; IntechOpen: London, UK, 2018. [Google Scholar] [CrossRef]
- Singhal, E.; Singh, R.; Bhardwaj, P.; Kumari, M. Candida Species in Catheter Associated Urinary Tract Infection in IcU Patients at a Tertiary Care Hospital in North India: An Observational Study. J. Med. Sci. Res. 2024, 12, 11–15. [Google Scholar] [CrossRef]
- Tosun Taşar, P.; Karasahin, O.; Karahan, B.; Kiziltunc, S.; Albayrak, A. Candidemia in Older Adults: What Are the Risk Factors for Mortality? Flora Infeks. Hastalik. Klin. Mikrobiyol. Derg. 2022, 27, 261–267. [Google Scholar] [CrossRef]
- Porto, A.P.M.; Borges, I.C.; Buss, L.; Machado, A.; Bassetti, B.R.; Cocentino, B.; Bicalho, C.S.; Carrilho, C.M.D.M.; Rodrigues, C.; Neto, E.A.S.; et al. Healthcare-Associated Infections on the Intensive Care Unit in 21 Brazilian Hospitals during the Early Months of the Coronavirus Disease 2019 (COVID-19) Pandemic: An Ecological Study. Infect. Control Hosp. Epidemiol. 2023, 44, 284–290. [Google Scholar] [CrossRef]
- Jain, M.; Dogra, V.; Mishra, B.; Thakur, A.; Loomba, S.L.; Bhargava, A. Candiduria in Catheterized Intensive Care Unit Patients: Emerging Microbiological Trends. Indian J. Pathol. Microbiol. 2011, 54, 552–555. [Google Scholar] [CrossRef]
- Obaid, N.A.; Almarzoky Abuhussain, S.; Mulibari, K.K.; Alshanqiti, F.; Malibari, S.A.; Althobaiti, S.S.; Alansari, M.; Muneef, E.; Almatrafi, L.; Alqarzi, A.; et al. Antimicrobial-Resistant Pathogens Related to Catheter-Associated Urinary Tract Infections in Intensive Care Units: A Multi-Center Retrospective Study in the Western Region of Saudi Arabia. Clin. Epidemiol. Glob. Health 2023, 21, 101291. [Google Scholar] [CrossRef]
- Mishra, N.; Kumari, D.; Mishra, A. Prevalence of Candida Species in Urinary Tract Infections from a Tertiary Care Hospital at Lucknow, Uttar Pradesh, India: A Retrospective Study. Natl. J. Lab. Med. 2022, 11, MO16–MO19. [Google Scholar] [CrossRef]
- Al-Berfkani, M.I.; Allu, M.A.; Mousa, S.A. The Effect of Climate Temperature and Daily Water Intake on the Diversity of Uropathogens Causing Urinary Tract Infections in Adult Hospital Patients. Diyala J. Med. 2016, 11, 62–69. [Google Scholar]
- Ionescu, A.C.; Brambilla, E.; Sighinolfi, M.C.; Mattina, R. A New Urinary Catheter Design Reduces In-Vitro Biofilm Formation by Influencing Hydrodynamics. J. Hosp. Infect. 2021, 114, 153–162. [Google Scholar] [CrossRef] [PubMed]
- Sun, M.; Geng, H.; Bai, J.; Feng, J.; Xu, N.; Liu, Y.; Liu, X.; Liu, G. Characterization of Cervical Canal and Vaginal Bacteria in Pregnant Women with Cervical Incompetence. Front. Microbiol. 2022, 13, 986326. [Google Scholar] [CrossRef] [PubMed]
- Slate, A.J.; Clarke, O.E.; Kerio, M.; Nzakizwanayo, J.; Patel, B.A.; Jones, B.V. Infection Responsive Coatings to Reduce Biofilm Formation and Encrustation of Urinary Catheters. J. Appl. Microbiol. 2023, 134, lxad121. [Google Scholar] [CrossRef] [PubMed]
- Singh, Y.; Karicheri, R.; Nath, D. The Burden of Catheter Associated Urinary Tract Infection by Candida albicans and Non Albicans with Emphasis on Biofilm Formation and Antifungal Sensitivity Pattern. Int. J. Health Sci. 2022, 6, 2356–2363. [Google Scholar] [CrossRef]
- Nguyen, T.T.; Palmer, S.C.; Cho, Y.; Mudge, D.W.; Strippoli, G.F.M.; Craig, J.C.; Johnson, D.W.; Htay, H. Peritoneal Dialysis: Infections. Evid.-Based Nephrol. 2022, 2, 138–155. [Google Scholar] [CrossRef]
- Couttenier, E.; Bachellier-Bassi, S.; d’Enfert, C.; Villard, C. Bending Stiffness of Candida albicans Hyphae as a Proxy of Cell Wall Properties. Lab Chip 2022, 22, 3898–3909. [Google Scholar] [CrossRef]
- Qiang, L.; Guo, J.; Han, Y.; Jiang, J.; Su, X.; Liu, H.; Qi, Q.; Han, L. A Novel Anti Candida albicans Drug Screening System Based on High-Throughput Microfluidic Chips. Sci. Rep. 2019, 9, 8087. [Google Scholar] [CrossRef]
- Maurer, M.; Gresnigt, M.S.; Last, A.; Wollny, T.; Berlinghof, F.; Pospich, R.; Cseresnyes, Z.; Medyukhina, A.; Graf, K.; Gröger, M.; et al. A Three-Dimensional Immunocompetent Intestine-on-Chip Model as in Vitro Platform for Functional and Microbial Interaction Studies. Biomaterials 2019, 220, 119396. [Google Scholar] [CrossRef]
- Claudel, J.; De Araujo, A.L.A.; Nadi, M. Lab-on-a-Chip Device for Yeast Cell Characterization in Low-Conductivity Media Combining Cytometry and Bio-Impedance. Sensors 2019, 19, 3366. [Google Scholar] [CrossRef]
- Tresso, K.A.; dos Santos, B.N.; Braga, F.T.M.M.; Margatho, A.S.; Mendes, K.D.S.; Silveira, R.C.d.C.P. Lock Therapy in Prevention and Treatment of Catheter-Associated Bloodstream Infection: Integrative Review. Acta Paul. Enferm. 2023, 36, eAPE01221. [Google Scholar] [CrossRef]
- Fakhim, H.; Vaezi, A.; Morovati, H.; Bandegani, A.; Abbasi, K.; Emami, S.; Nasiry, D.; Hashemi, S.M.; Ahangarkani, F.; Badali, H. In-Vivo Efficiency of the Novel Azole Compounds (ATTAF-1 and ATTAF-2) against Systemic Candidiasis in a Murine Model. J. Med. Mycol. 2023, 33, 101437. [Google Scholar] [CrossRef] [PubMed]
- Petraitiene, R.; Petraitis, V.; Zaw, M.H.; Hussain, K.; Ricart Arbona, R.J.; Roilides, E.; Walsh, T.J. Combination of Systemic and Lock-Therapies with Micafungin Eradicate Catheter-Based Biofilms and Infections Caused by Candida albicans and Candida parapsilosis in Neutropenic Rabbit Models. J. Fungi 2024, 10, 293. [Google Scholar] [CrossRef] [PubMed]
- van der Sluijs, A.v.E.; Eekelschot, K.Z.A.J.; Frakking, F.N.J.; Haas, P.J.A.; Boer, W.H.; Abrahams, A.C. Salvage of the Peritoneal Dialysis Catheter in Candida peritonitis Using Amphotericin B Catheter Lock. Perit. Dial. Int. 2021, 41, 110–114. [Google Scholar] [CrossRef] [PubMed]
- Mullins, C.; Beaulac, K.; Sylvia, L. Drug-Induced Liver Injury (DILI) With Micafungin: The Importance of Causality Assessment. Ann. Pharmacother. 2020, 54, 526–532. [Google Scholar] [CrossRef]
- Kovács, R.; Majoros, L. Antifungal Lock Therapy: An Eternal Promise or an Effective Alternative Therapeutic Approach? Lett. Appl. Microbiol. 2022, 74, 851–862. [Google Scholar] [CrossRef]
- Wunnoo, S.; Paosen, S.; Lethongkam, S.; Sukkurd, R.; Waen-ngoen, T.; Nuidate, T.; Phengmak, M.; Voravuthikunchai, S.P. Biologically Rapid Synthesized Silver Nanoparticles from Aqueous Eucalyptus camaldulensis Leaf Extract: Effects on Hyphal Growth, Hydrolytic Enzymes, and Biofilm Formation in Candida albicans. Biotechnol. Bioeng. 2021, 118, 1578–1592. [Google Scholar] [CrossRef]
- Li, W.R.; Shi, Q.S.; Dai, H.Q.; Liang, Q.; Xie, X.B.; Huang, X.M.; Zhao, G.Z.; Zhang, L.X. Antifungal Activity, Kinetics and Molecular Mechanism of Action of Garlic Oil against Candida albicans. Sci. Rep. 2016, 6, 22805. [Google Scholar] [CrossRef]
- Ashrit, P.; Sadanandan, B.; Shetty, K.; Vaniyamparambath, V. Polymicrobial Biofilm Dynamics of Multidrug-Resistant Candida albicans and Ampicillin-Resistant Escherichia coli and Antimicrobial Inhibition by Aqueous Garlic Extract. Antibiotics 2022, 11, 573. [Google Scholar] [CrossRef]
- Sadanandan, B.; Prerna, L.; Humtsoe, H.M.A. Antibacterial Activity of Garlic against Bacillus subtilis. Int. Rev. Appl. Biotechnol. Biochem. 2014, 2, 107–119. [Google Scholar]
- El-Baz, A.M.; Mosbah, R.A.; Goda, R.M.; Mansour, B.; Sultana, T.; Dahms, T.E.S.; El-Ganiny, A.M. Back to Nature: Combating Candida albicans Biofilm, Phospholipase and Hemolysin Using Plant Essential Oils. Antibiotics 2021, 10, 81. [Google Scholar] [CrossRef]
- Kumar, G.; Madka, V.; Pathuri, G.; Ganta, V.; Rao, C.V. Molecular Mechanisms of Cancer Prevention by Gooseberry (Phyllanthus emblica). Nutr. Cancer 2022, 74, 2291–2302. [Google Scholar] [CrossRef] [PubMed]
- Rouf, R.; Uddin, S.J.; Sarker, D.K.; Islam, M.T.; Ali, E.S.; Shilpi, J.A.; Nahar, L.; Tiralongo, E.; Sarker, S.D. Antiviral Potential of Garlic (Allium sativum) and Its Organosulfur Compounds: A Systematic Update of Pre-Clinical and Clinical Data. Trends Food Sci. Technol. 2020, 104, 219–234. [Google Scholar] [CrossRef] [PubMed]
- Sarangi, A.; Das, B.S.; Sahoo, A.; Jena, B.; Patnaik, G.; Giri, S.; Chattopadhyay, D.; Bhattacharya, D. Deciphering the Antibiofilm, Antibacterial, and Antioxidant Potential of Essential Oil from Indian Garlic and Its Phytocompounds Against Foodborne Pathogens. Curr. Microbiol. 2024, 81, 245. [Google Scholar] [CrossRef] [PubMed]
- Somayeh, S.M.; Samaneh, M.A.; Pedram, E.; Zahra, M.; Maliheh, N. Anti-Bacterial Property and Cytotoxicity of Allium sativum and Myrtus communis Extracts Against Nosocomial Bacterial Infections. Iran. J. Toxicol. 2023, 17, 71–78. [Google Scholar]
- Li, Z.; Li, Z.; Yang, J.; Lu, C.; Li, Y.; Luo, Y.; Cong, F.; Shi, R.; Wang, Z.; Chen, H.; et al. Allicin Shows Antifungal Efficacy against Cryptococcus neoformans by Blocking the Fungal Cell Membrane. Front. Microbiol. 2022, 13, 1012516. [Google Scholar] [CrossRef]
- Kuda, T.; Iwai, A.; Yano, T. Effect of Red Pepper Capsicum annuum Var. Conoides and Garlic Allium sativum on Plasma Lipid Levels and Cecal Microflora in Mice Fed Beef Tallow. Food Chem. Toxicol. 2004, 42, 1695–1700. [Google Scholar] [CrossRef]
- Tavares, L.; Santos, L.; Zapata Noreña, C.P. Bioactive Compounds of Garlic: A Comprehensive Review of Encapsulation Technologies, Characterization of the Encapsulated Garlic Compounds and Their Industrial Applicability. Trends Food Sci. Technol. 2021, 114, 232–244. [Google Scholar] [CrossRef]
- Oosthuizen, C.B.; Reid, A.M.; Lall, N. Garlic (Allium sativum) and Its Associated Molecules, as Medicine. In Medicinal Plants for Holistic Health and Well-Being; Academic Press: Cambridge, MA, USA, 2018; pp. 277–295. [Google Scholar] [CrossRef]
- Pandey, V.K.; Srivastava, S.; Ashish; Dash, K.K.; Singh, R.; Dar, A.H.; Singh, T.; Farooqui, A.; Shaikh, A.M.; Kovacs, B. Bioactive Properties of Clove (Syzygium aromaticum) Essential Oil Nanoemulsion: A Comprehensive Review. Heliyon 2024, 10, e22437. [Google Scholar] [CrossRef]
- Moradi, E.; Rakhshandeh, H.; Rahimi Baradaran, V.; Ghadiri, M.; Hasanpour, M.; Iranshahi, M.; Askari, V.R. HPLC/MS Characterization of Syzygium aromaticum L. and Evaluation of Its Effects on Peritoneal Adhesion: Investigating the Role of Inflammatory Cytokines, Oxidative Factors, and Fibrosis and Angiogenesis Biomarkers. Physiol. Rep. 2023, 11, e15584. [Google Scholar] [CrossRef]
- Haleema Shahin, D.H.; Sultana, R.; Farooq, J.; Taj, T.; Khaiser, U.F.; Alanazi, N.S.A.; Alshammari, M.K.; Alshammari, M.N.; Alsubaie, F.H.; Asdaq, S.M.B.; et al. Insights into the Uses of Traditional Plants for Diabetes Nephropathy: A Review. Curr. Issues Mol. Biol. 2022, 44, 2887–2902. [Google Scholar] [CrossRef]
- Boonpisuttinant, K.; Ruksiriwanich, W.; Chutoprapat, R.; Udompong, S.; Kansawang, R.; Sangsee, J.; Chompoo, W.; Samothai, K.; Srisut, R. Assessment of in Vitro Anti-Skin Ageing Activities of Giant Indian Gooseberry (Phyllanthus indofischeri Bennet) Extracts for Dermatological Health and Aesthetic Applications. Res. Sq. 2023. preprint. [Google Scholar] [CrossRef]
- Feneley, R.C.L.; Hopley, I.B.; Wells, P.N.T. Urinary Catheters: History, Current Status, Adverse Events and Research Agenda. J. Med. Eng. Technol. 2015, 39, 459–470. [Google Scholar] [CrossRef]
- Farrag, H.A.; El, A.; Ali, H.; Farrag, H.A.; El-Dien, A.; Hosny, M.S.; Hagras, S.A.A. Elimination and Prevention of Microbial Colonization of Central Venous Catheters Using Antibiotic Lock Technique and NonLeachable Form of Catheter Surface Incorporated Antibiotic b Elimination and Prevention of Microbial Colonization of Central Venous Catheters Using Antibiotic Lock Technique and Non-Leachable Form of Catheter Surface Incorporated Antibiotic by Gamma Radiation. Artic. IOSR J. Pharm. Biol. Sci. 2014, 9, 28–37. [Google Scholar] [CrossRef]
- Freire, M.P.; Pierrotti, L.C.; Zerati, A.E.; Benites, L.; Da Motta-Leal Filho, J.M.; Ibrahim, K.Y.; Araujo, P.H.; Abdala, E. Role of Lock Therapy for Long-Term Catheter-Related Infections by Multidrug-Resistant Bacteria. Antimicrob. Agents Chemother. 2018, 62, e00569-18. [Google Scholar] [CrossRef] [PubMed]
- Ko, K.S.; Lee, J.Y.; Song, J.H.; Peck, K.R. In Vitro Evaluation of Antibiotic Lock Technique for the Treatment of Candida albicans, C. Glabrata, and C. Tropicalis Biofilms. J. Korean Med. Sci. 2010, 25, 1722–1726. [Google Scholar] [CrossRef]
- Kovács, R.; Nagy, F.; Tóth, Z.; Bozó, A.; Balázs, B.; Majoros, L. Synergistic Effect of Nikkomycin Z with Caspofungin and Micafungin against Candida albicans and Candida parapsilosis Biofilms. Lett. Appl. Microbiol. 2019, 69, 271–278. [Google Scholar] [CrossRef]
- Öncu, S. In Vitro Effectiveness of Antifungal Lock Solutions on Catheters Infected with Candida Species. J. Infect. Chemother. 2011, 17, 634–639. [Google Scholar] [CrossRef]
- Sadanandan, B.; Vijayalakshmi, V.; Ashrit, P.; Babu, U.V.; Kumar, L.M.S.; Sampath, V.; Shetty, K.; Joglekar, A.P.; Awaknavar, R. Aqueous Spice Extracts as Alternative Antimycotics to Control Highly Drug Resistant Extensive Biofilm Forming Clinical Isolates of Candida albicans. PLoS ONE 2023, 18, e0281035. [Google Scholar] [CrossRef]
- Dabur, R.; Gupta, A.; Mandal, T.K.; Singh, D.D.; Bajpai, V.; Gurav, A.M.; Lavekar, G.S. Antimicrobial Activity of Some Indian Medicinal Plants. Afr. J. Tradit. Complement. Altern. Med. 2007, 4, 313. [Google Scholar] [CrossRef]
- Sampaio, A.d.G.; Gontijo, A.V.L.; Lima, G.d.M.G.; de Oliveira, M.A.C.; Lepesqueur, L.S.S.; Koga-Ito, C.Y. Ellagic Acid–Cyclodextrin Complexes for the Treatment of Oral Candidiasis. Molecules 2021, 26, 505. [Google Scholar] [CrossRef]
- Khounganian, R.M.; Alwakeel, A.; Albadah, A.; Nakshabandi, A.; Alharbi, S.; Almslam, A.S. The Antifungal Efficacy of Pure Garlic, Onion, and Lemon Extracts Against Candida albicans. Cureus 2023, 15, e38637. [Google Scholar] [CrossRef] [PubMed]
- Biernasiuk, A.; Baj, T.; Malm, A. Clove Essential Oil and Its Main Constituent, Eugenol, as Potential Natural Antifungals against Candida spp. Alone or in Combination with Other Antimycotics Due to Synergistic Interactions. Molecules 2023, 28, 215. [Google Scholar] [CrossRef] [PubMed]
- Rajkowska, K.; Otlewska, A.; Kunicka-Styczyńska, A.; Krajewska, A. Candida albicans Impairments Induced by Peppermint and Clove Oils at Sub-Inhibitory Concentrations. Int. J. Mol. Sci. 2017, 18, 1307. [Google Scholar] [CrossRef] [PubMed]
- Khurana, S.K.; Tiwari, R.; Sharun, K.; Iqbal Yatoo, M.; Gugjoo, M.B.; Dhama, K. Emblica officinalis (Amla) with a Particular Focus on Its Antimicrobial Potentials: A Review. J. Pure Appl. Microbiol. 2019, 13, 1995–2012. [Google Scholar] [CrossRef]
- Tsegay, Z.T.; Mulaw, G. Antimicrobial Activities and Mode of Action of Bioactive Substances from Vegetable and Fruit Byproducts as a Current Option for Valorization. Waste Biomass Valoriz. 2024, 1–28. [Google Scholar] [CrossRef]
- Sahidur, M.R.; Islam, S.; Jahurul, M.H.A. Garlic (Allium sativum) as a Natural Antidote or a Protective Agent against Diseases and Toxicities: A Critical Review. Food Chem. Adv. 2023, 3, 100353. [Google Scholar] [CrossRef]
- Didehdar, M.; Chegini, Z.; Shariati, A. Eugenol: A Novel Therapeutic Agent for the Inhibition of Candida Species Infection. Front. Pharmacol. 2022, 13, 872127. [Google Scholar] [CrossRef]
- Ferreira, J.A.G.; Carr, J.H.; Starling, C.E.F.; De Resende, M.A.; Donlan, R.M. Biofilm Formation and Effect of Caspofungin on Biofilm Structure of Candida Species Bloodstream Isolates. Antimicrob. Agents Chemother. 2009, 53, 4377. [Google Scholar] [CrossRef]
- Sieuwerts, S.; De Bok, F.A.M.; Mols, E.; De Vos, W.M.; Van Hylckama Vlieg, J.E.T. A Simple and Fast Method for Determining Colony Forming Units. Lett. Appl. Microbiol. 2008, 47, 275–278. [Google Scholar] [CrossRef]
- LaFleur, M.D.; Kumamoto, C.A.; Lewis, K. Candida albicans Biofilms Produce Antifungal-Tolerant Persister Cells. Antimicrob. Agents Chemother. 2006, 50, 3839–3846. [Google Scholar] [CrossRef]
- Mukherjee, P.K.; Long, L.; Kim, H.G.; Ghannoum, M.A. Amphotericin B Lipid Complex Is Efficacious in the Treatment of Candida albicans Biofilms Using a Model of Catheter-Associated Candida Biofilms. Int. J. Antimicrob. Agents 2009, 33, 149–153. [Google Scholar] [CrossRef] [PubMed]
- Latti, P.; Ramanarayanan, S.; Prashant, G.M. Antifungal Efficacy of Spice Extracts against Candida albicans: An In Vitro Study. Indian J. Community Med. 2019, 44, S77–S80. [Google Scholar] [CrossRef] [PubMed]
- Marian, M.; Roşca, O.M.; Mihalescu, L.; Voşgan, Z.; Lazăr, A. Antifungal Effect of Spice Extracts—Possible Solutions for Biological Preservation of Food. Food Environ. Saf. J. 2018, 17, 103. [Google Scholar]
- El-Mougy, N.S.; Abdel-Kader, M.M. Antifungal Effect of Powdered Spices and Their Extracts on Growth and Activity of Some Fungi in Relation to Damping-off Disease Control. J. Plant Prot. Res. 2007, 47, 267–278. Available online: https://www.plantprotection.pl/Antifungal-effect-of-powdered-spices-and-their-extracts-on-growth-and-activity-of,91115,0,2.html (accessed on 14 December 2024).
- Thyagaraja, N.; Hosono, A. Effect of Spice Extract on Fungal Inhibition. LWT-Food Sci. Technol. 1996, 29, 286–288. [Google Scholar] [CrossRef]
- Walraven, C.J.; Lee, S.A. Antifungal Lock Therapy. Antimicrob. Agents Chemother. 2012, 57, 1–8. [Google Scholar] [CrossRef]
- Paul Dimondi, V.; Townsend, M.L.; Johnson, M.; Durkin, M. Antifungal Catheter Lock Therapy for the Management of a Persistent Candida albicans Bloodstream Infection in an Adult Receiving Hemodialysis. Pharmacother. J. Hum. Pharmacol. Drug Ther. 2014, 34, e120–e127. [Google Scholar] [CrossRef]
- Srinivasan, A.; Uppuluri, P.; Lopez-Ribot, J.; Ramasubramanian, A.K. Development of a High-Throughput Candida albicans Biofilm Chip. PLoS ONE 2011, 6, e19036. [Google Scholar] [CrossRef]
- Srinivasan, A.; Lopez-Ribot, J.L.; Ramasubramanian, A.K. Candida albicans Biofilm Chip (CaBChip) for High-Throughput Antifungal Drug Screening. J. Vis. Exp. 2012, 65, e3845. [Google Scholar] [CrossRef]
- Asghar, W.; Sher, M.; Khan, N.S.; Vyas, J.M.; Demirci, U. Microfluidic Chip for Detection of Fungal Infections. ACS Omega 2019, 4, 7474–7481. [Google Scholar] [CrossRef]
Disclaimer/Publisher’s Note: The statements, opinions and data contained in all publications are solely those of the individual author(s) and contributor(s) and not of MDPI and/or the editor(s). MDPI and/or the editor(s) disclaim responsibility for any injury to people or property resulting from any ideas, methods, instructions or products referred to in the content. |
© 2025 by the authors. Licensee MDPI, Basel, Switzerland. This article is an open access article distributed under the terms and conditions of the Creative Commons Attribution (CC BY) license (https://creativecommons.org/licenses/by/4.0/).